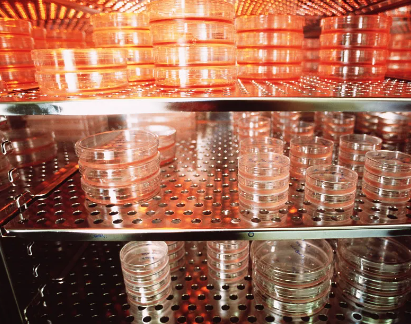
image.png

大口徑干細(xì)胞容器生產(chǎn)商
2024-10-14 11:18:40 來源: 小編 咨詢醫(yī)生
然而,我可以為你提供一個大致的排名概述和一些主要的干細(xì)胞企業(yè),你可以根據(jù)這些信息進(jìn)一步研究:
1.北京協(xié)和干細(xì)胞基因工程有限公司:作為中國先進(jìn)的干細(xì)胞治療研究機構(gòu),其在干細(xì)胞領(lǐng)域的科研成果顯著。
2.上海交通大學(xué)醫(yī)學(xué)院附屬瑞金醫(yī)院再生醫(yī)學(xué)中心:該中心在干細(xì)胞研究和臨床應(yīng)用方面具有很高的聲譽。
3.北京三一生物科技股份有限公司:專注于干細(xì)胞技術(shù)的研發(fā)和產(chǎn)業(yè)化,產(chǎn)品線涵蓋干細(xì)胞儲存、培養(yǎng)和移植。
4.中科院昆明動物研究所:以基礎(chǔ)研究和轉(zhuǎn)化醫(yī)學(xué)為主,是國家干細(xì)胞與再生醫(yī)學(xué)研究中心。
5.廣州博濟生物醫(yī)藥股份有限公司:致力于干細(xì)胞治療產(chǎn)品的研發(fā),包括CAR-T細(xì)胞療法等。
6.浙江九州細(xì)胞生命科技有限公司:專注于干細(xì)胞治療和再生醫(yī)學(xué),擁有完整的產(chǎn)業(yè)鏈。
7.深圳賽為康生物科技有限公司:主要從事干細(xì)胞存儲、基因編輯及細(xì)胞治療的研發(fā)和生產(chǎn)。
8.吉林省博泰生物科技股份有限公司:專注于干細(xì)胞技術(shù)的研發(fā)和應(yīng)用,特別是在骨髓干細(xì)胞領(lǐng)域。
9.廣東康達(dá)干細(xì)胞技術(shù)有限公司:提供干細(xì)胞儲存、研究和治療服務(wù),與多家醫(yī)療機構(gòu)合作。
10.河北百齡細(xì)胞生物科技有限公司:河北百齡細(xì)胞生物科技有限公司(簡稱“百齡干細(xì)胞”),是一家集干細(xì)胞與免疫細(xì)胞儲存、研發(fā)、制備及應(yīng)用于一身的綜合性生物科技企業(yè),尤其在再生醫(yī)學(xué)、健康管理與抗衰老領(lǐng)域?qū)崿F(xiàn)了產(chǎn)業(yè)鏈一體化布局。公司在石家莊建立了符合GMP標(biāo)準(zhǔn)的實驗室,其細(xì)胞儲存業(yè)務(wù)獲得了中國人保PICC的承保,確保了細(xì)胞產(chǎn)品的安全保障。
這只是部分排名,實際上,隨著干細(xì)胞技術(shù)的發(fā)展,國內(nèi)還有許多其他優(yōu)秀的公司正在嶄露頭角。在選擇具體企業(yè)時,建議關(guān)注企業(yè)的科研實力、技術(shù)優(yōu)勢、臨床試驗進(jìn)展以及行業(yè)認(rèn)可度等因素。同時,由于干細(xì)胞行業(yè)的動態(tài)性,實際排名可能有所變化,建議查詢最新的行業(yè)報告或咨詢專業(yè)人士獲取最準(zhǔn)確的信息。
-
上一頁: 大口徑干細(xì)胞容器公司
-
下一頁: 干細(xì)胞容器公司
- 2024-10-18干細(xì)胞治療神經(jīng)系統(tǒng)障礙有效嗎,干細(xì)胞治療神經(jīng)系統(tǒng)障礙的潛力分析
- 2024-10-08南京牙髓干細(xì)胞作用大嗎?在臨床上有何應(yīng)用?
- 2024-10-24造血干細(xì)胞移植過程中尿血是什么原因?如何處理?
- 2024-09-18自體干細(xì)胞移植的危害有多大,技術(shù)成熟嗎
- 2024-10-21臍帶血干細(xì)胞可以治療什么病,臍帶血干細(xì)胞的臨床應(yīng)用進(jìn)展
- 2024-08-10自體造血干細(xì)胞移植排異反應(yīng)大嗎
- 2024-09-20福州總醫(yī)院干細(xì)胞移植費用多少錢
- 2024-09-13干細(xì)胞移植后血小板低怎么辦,試試這些解決方法
- 2024-08-07干細(xì)胞抗衰老多少錢,干細(xì)胞抗衰老持續(xù)效果怎么樣
- 2024-09-16干細(xì)胞療法上市藥物,中國批準(zhǔn)的干細(xì)胞藥物
- 2024-07-29造血干細(xì)胞捐獻(xiàn)流程,造血干細(xì)胞捐獻(xiàn)年齡范圍
- 2024-09-12干細(xì)胞療法為啥叫停,國家為什么不允許打干細(xì)胞
- 2024-09-09深圳儲存干細(xì)胞費用,多少錢一年
- 2024-08-02自體干細(xì)胞療法,自體干細(xì)胞移植需要多少錢
- 2024-09-07干細(xì)胞技術(shù)高度近視能恢復(fù)嗎,何時可以臨床
- 2024-09-06干細(xì)胞具有什么功效,詳解主要功效和副作用
- 2024-09-11干細(xì)胞抗衰老最新成果,這些方面取得重大突破
- 2024-08-05干細(xì)胞治療卵巢早衰,卵巢干細(xì)胞一針多少錢
